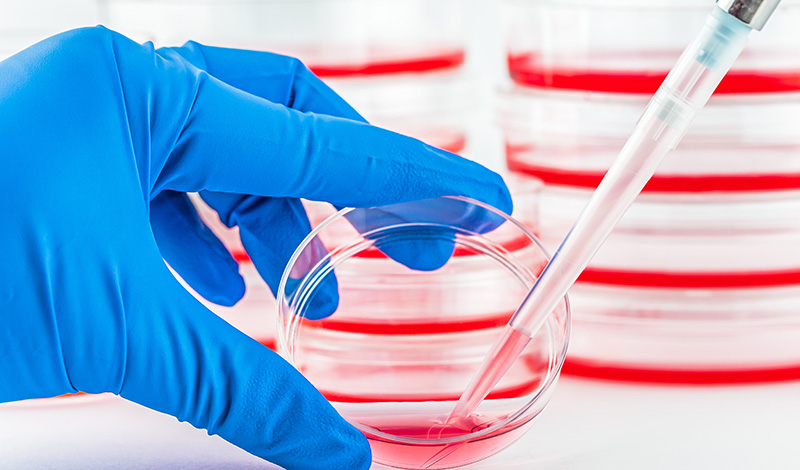

Complete HHV Solutions Portfolio
Antiviral Drug Discovery Solutions
Our antiviral programs support each phase of preclinical development:
- Target Identification & Validation: Leverage our high-throughput screening platforms and bioinformatics pipelines to discover and confirm novel antiviral targets within HHV genomes.
- Hit-to-Lead Generation: Accelerate the development of lead compounds using validated cell-based assays, viral yield reduction tests, and EC50/IC50 profiling.
- Pre-clinical Candidate Nomination: Comprehensive pharmacological and safety assessment to enable candidate advancement.
- Latency-Targeting Solutions: Unique assays and cell models to study and disrupt HHV latency, including KSHV and EBV models.
Vaccine Development Solutions
We support full-cycle vaccine research against HHVs:
- Antigen Discovery & Design: Using epitope prediction, structural modeling, and immunoinformatics tools.
- Vaccine Candidate Construction: Includes protein subunits, VLPs, and nucleic acid-based platforms.
- Adjuvant & Formulation Screening: Compatibility studies with proprietary and commercial adjuvants.
- Pre-clinical Immunogenicity & Efficacy Testing: In vitro and in vivo systems for neutralizing antibody and cellular immunity assessment.
Diagnostic Development Solutions
Speed up the development of molecular and immunodiagnostic assays:
- Biomarker Discovery & Validation: Multi-omics approaches to identify viral and host response signatures.
- Assay Development Support: From primer/probe design to assay optimization for qPCR, ELISA, or lateral flow formats.
Gene Therapy Development Solutions
Leverage viral vectors for gene delivery in HHV research and therapy:
- Vector Construction: Recombinant AAV, lentivirus, and HSV vectors engineered for HHV target modulation.
- In Vivo Delivery & Expression Verification: Biodistribution, expression, and safety evaluations in relevant models.
Oncolytic Virus (oHSV) Therapy Solutions
We provide comprehensive oHSV-based therapeutic development support:
- oHSV Engineering & Validation: Including immune-modulating gene insertion and safety attenuation.
- In Vitro & In Vivo Activity: Tumor lysis assessment, replication efficiency, and viral kinetics.
- Immune Profiling: Host immune response analysis via flow cytometry, cytokine profiling, and transcriptomics.
- Biodistribution & Shedding Studies: Required for preclinical safety and regulatory filings.
Custom Research Project Solutions
Looking for something unique? We provide fully customizable project design, protocol optimization, and execution to support your HHV hypothesis—from bench to publication or IND-enabling data.
Core Service Capabilities
Virology Services
- Virus Production & Titration: High-titer stocks of all nine HHV types, quantified via plaque assay or TCID50.
- Virus Purification & Characterization: Density gradient purification and electron microscopy.
- HHV Genome Sequencing: Long-read and short-read options.
- Custom Virus Engineering: Knock-in/knock-out, mutagenesis, and reporter insertion.


In Vitro Antiviral Profiling
- High-Throughput Screening (HTS): Compound libraries screened against HHV-infected cells.
- Mechanism of Action Studies: Lifecycle stage–specific assays including entry, replication, and egress.
- Resistance Profiling: Passaging-based resistance and genotypic/phenotypic assays.
Vaccine and Immunology Testing
- Neutralizing Antibody Titer (NT50) Assays
- T cell cytokine profiling via ELISpot or flow cytometry
- Challenge studies in immunocompetent or humanized animal models


Preclinical Animal Models
- Latency Models: Including KSHV/PEL, EBV/B-cell lymphoma models.
- Acute Infection Models: HSV-1 skin lesion model, CMV systemic infection in NHPs.
- Humanized Mouse Models: To evaluate immune response and antiviral efficacy.
Safety, Toxicology & Bioanalytics
- In Vitro Cytotoxicity: MTT, LDH release, organoid-based systems.
- In Vivo Toxicology: Dose range finding, repeat-dose studies, GLP-compliant reports.
- Bioanalytical Services: PK, TK, ADA, viral load quantification (qPCR/ddPCR), biodistribution, and shedding.

Specialized HHV Research Products

Viral Reagents
- Wild-type HHV strains: HSV-1, HSV-2, VZV, CMV, EBV, KSHV, HHV-6A/B, HHV-7
- Reporter Viruses: Luciferase, GFP, β-galactosidase tagged for high-throughput screening
Cell Lines & Media
- Virus propagation cell lines
- Stable lines expressing HHV proteins
- Primary Cells
- Specialized Cell Culture Media & Supplements

Molecular Tools
- Plasmids for HHV gene expression, CRISPR tools
- Primers & Probes

Proteins & Antibodies
- Recombinant Viral Proteins
- Antibodies

Assay Kits
- ELISA kits
- qPCR kits
- Neutralization Assay Kits
- Viral Entry/Fusion Assay Kits
Why CD BioSciences?
- Niche Focus: 100% dedicated to HHV—no distractions, total depth.
- Scientific Expertise: Our teams are trained in HHV biology, antiviral pharmacology, immunology, and translational virology.
- Integrated Offerings: Solutions, services, and products under one roof.
- Regulatory Awareness: We generate IND-enabling and publication-quality data.
- Global Reach: We support clients across North America and Europe with fast turnaround, reliable logistics, and responsive project teams.
Need help with a specific HHV project? Get in touch to discuss custom solutions.
References
- Whitley RJ, Roizman B. Herpes simplex viruses. In: Fields Virology. 6th ed. Lippincott Williams & Wilkins; 2013.
- Mocarski ES, et al. Cytomegaloviruses. In: Fields Virology. 6th ed.
- Cesarman E. Gammaherpesviruses and lymphoproliferative disorders. Annu Rev Pathol. 2014;9:349–372.
- Fowler KB, et al. Congenital CMV infection. Clin Infect Dis. 2017;64(8):1113–1119.
- Thompson MP, Kurzrock R. Epstein-Barr virus and cancer. Clin Cancer Res. 2004;10(3):803–821.
- Dittmer DP. Discovery of HHV-8 and its role in Kaposi's Sarcoma. Curr Opin Oncol. 2011;23(5):488–493.
